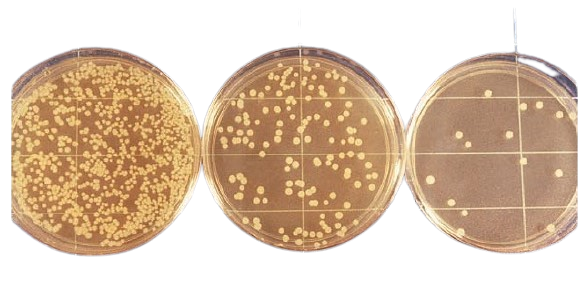
Agar plates plated with serial dilution of test sample - Agar plates plated with serial dilution of the test sample

Serial dilution is a series of sequential dilutions, each with the same dilution factor, where the diluted material of the previous step is used to make the subsequent dilution.
In microbiology, serial dilution estimates viable organisms (number of yeasts, bacteria, viruses, or bacteriophage) present in a sample by backtracking the measured concentration of the most diluted solution to the unknown concentration.
Understanding Basics of Dilution
(In this section, I am discussing very basic information about dilution and terminologies. If you are already familiar with the basics, you can directly jump to preparing serial dilution).
Let’s say you have a glass of sugar solution at 6.0 M concentration and another glass with water. If you took 1 mL of sugar solution and dispensed it in a new tube, then added 9 mL of water and mixed. You just made a dilution.
To calculate the dilution factor (df), you need to divide the solution’s total volume by the sample volume (i.e., sugar solution in this case).
Total volume = (Volume of sample + Volume of diluent), i.e., 1 mL sugar solution + 9 mL water = 10 mL
Dilution Factor = Total volume/Sample volume = 10/1= 10
This dilution can be expressed by various terms like
- The dilution factor is 10 (dilution factor is the reciprocal of the dilution)
- It was a 10-fold dilution
- It was diluted by 1/10.
Calculating the concentration
To calculate the concentration of this diluted sample, multiply by the inverse of the dilution factor.
Final concentration = (Initial concentration X 1/ dilution factor), i.e., 0.6 M
Sometimes, you may wish to calculate backward. Let’s say you have a sample that has been diluted 1/10 with a concentration of 0.6 M and wants to calculate its undiluted concentration.
Undiluted concentration = (Diluted concentration X dilution factor)
= 0.6 M *10 = 6M.
In this example, we have used sugar solution as a sample and water as a diluent. In a real-world example, the sample can be an antibiotic solution, a patient specimen, food items, or drinking water. The diluent may be water, a buffer solution, or an actual growth medium.
Multiple or Serial Dilution
Let’s say you again diluted the sugar solution by taking 1 ml of diluted sugar solution in another 9 mL of water. Your final dilution ends up being 1/10 X 1/10 = 1/100 dilution. In other words, your sample has been diluted 100-fold (d.f. =100).
| Dilution Fold | Volume of Sample or Stock Solution | Volume of Diluent | Final Volume |
|---|---|---|---|
| 2 Fold Dilution | 5 mL | 5 mL | 10 mL |
| 10 Fold Dilution | 1 mL | 9 mL | 10 mL |
| 100 Fold Dilution | 0.1 mL | 9.9 mL | 10 mL |
If you want to measure the concentration of the final solution after two successive 10-fold dilutions, follow the same formula: (6 M X1/10 X 1/10) = 6/100 = 0.06 M
So, If you need 100-fold (10-2) dilution, you can either add 0.1 mL sample with 9.9 mL of diluent or make two successive 10-fold dilutions.
Similarly, if you need 10-6(1/106) dilution, you can make three successive 10-2(1/102) dilutions or six successive 10-1 dilutions.
Before preparing a dilution, prepare a table like this to avoid confusion or mistakes in diluting the sample.
Equipment
- Petri dishes, glass or plastic (at least 15 × 90 mm)
- Pipets with pipet aids or pipettors, 1, 5, and 10 ml, graduated in 0.1 ml units
- Erlenmeyer flask
- Dilution bottles
- Pipet and petri dish containers, adequate for protection
- Circulating water bath
- Incubator
- Colony counter
- Tally register
- Dilution blanks
- Plate count agar (PCA)
- Refrigerator
- Test tubes
- Vortex
Preparing Serial Dilution
In this example, 1 mL of the original sample is taken from a broth culture and added to 9 mL of sterile water, thereby diluting the culture by a factor of 10. This process is repeated until the desired concentration is reached.
Preparation of diluent
- Prepare six test tubes that can store 20 mL or more in a rack and label them T1-T6. Each tube is consistent with the dilution factor it corresponds to (i.e., T3= 1×103 OR 0.001th of stock concentration).
- Pipet 9 mL of sterile water, saline, or broth into each of the 10 test tubes.
- Sterilize the diluent banks by autoclave. Use aluminum foil to cover each of the six test tubes and then transfer them to an autoclave-compatible test tube rack. Sterilize for a minimum of 15 minutes at 121**°**C, 15 PSI.
- Remove blanks using heat-resistant gloves and allow to cool. When tubes reach room temperature, cover and store at 4**°**C until needed.
Serial Dilution Method
- Obtain the sample flask from the incubator and shake it vigorously.
- Pipet 1 mL of “solution” into the test tube labeled T1. Vortex T1.
- Remove 1 mL from test tube T1 and add it to test tube T2. Vortex T2.
- Remove 1 mL from test tube T2 and add it to test tube T3. Vortex T3.
- Remove 1 mL from test tube T3 and add it to test tube T4. Vortex T4.
- Remove 1 mL from test tube T4 and add it to test tube T5. Vortex T5.
- Remove 1 mL from test tube T5 and add it to test tube T6. Vortex T6.

Plating into the Media
Thus prepared samples can be plated to culture media via the pour plate or spread plate technique. The procedure of the spread plate technique is mentioned here.
- Pipet 0.1 mL of a diluted sample from T1 directly onto a petri dish labeled P1. Repeat this step with each tube and plate to the corresponding petri dish (T2 to P2, T3 to P3, and so on).
- Obtain a sterile, disposable spreading rod or flame sterilize a glass spreading rod.
- In a clockwise or counterclockwise motion, glide the horizontal portion of the spreading rod to equally distribute the sample through the petri dish’s surface.
- Incubate plates in a 37 incubator for 24 hours.
Find more about the spread plate technique in this blog: Spread Plate Technique: Principle, Procedure, Results
If you want to try the pour plate procedure and also want to know more about this technique, visit this blog: Pour Plate Method: Procedure, Uses, (Dis) Advantages
Counting Number of Organisms
After 24 hours of incubation, remove the plate from the incubator and count the number of colonies using colony counter. The usual practice is to count colonies only on plates that have between 30 to 300 colonies.
Calculate the number of bacteria present in the original sample is calculated by multiplying the number of colonies formed with the dilution factor.
In this example, we found that the sample contains 3.11 X 105 bacteria per mL.
Notes
- Refrain from estimating colonies count by counting >300 colonies or <30 colonies on the agar plate, as it leads to a high degree of error. A high count can be confounded by the error in counting too many small colonies or difficulty in counting overlapping colonies.
- Use separate sterile pipettes for each dilution. To do otherwise will increase the chances of inaccuracy because of the carry-over of organisms.
- Accuracy in quantitation is determined by accurate pipette use and adequate agitation of dilution tubes.
Uses of Serial Dilution Method
Serial dilution is one of the most important skills a biology graduate must develop. It has wide applications in various disciplines of biology. It is used for isolating and quantitating the number of microorganisms present in various samples such as water, food, etc.
Serial dilution skill is required for bioburden testing, minimum inhibitory concentration (MIC), most probable number method (MPN), determination of antibody titer, and determination of minimum lethal dose.
To obtain a pure culture of microorganisms
Serial dilution method is routinely used to obtain a pure culture of microorganisms from mixed cultures. A series of dilutions are made from the sample and plated in the culture medium either by spread plate or by pour plate method.
Some of the resulting plates will contain a countable number of bacterial colonies on the agar. Each colony represents a pure growth, also known as a colony forming unit (CFU), that arises from a single bacterium.
Estimation of viable cell numbers
Serial dilution technique is widely used to estimate viable cell numbers in the standard plate count method and most probable number (MPN) technique. MPN methods are used for estimating the number of microorganisms in foods, wastewater, and other samples in which cell numbers need to be assessed routinely.
Standard plate count is used for estimating the number of viable organisms present in a sample.****Because one may not know the approximate viable count ahead of time, multiple 10-fold dilutions of the sample are made and plated into the agar medium.
MIC and MBC Determination
The MIC and MBC determination procedure employs an antibiotic dilution assay in agar, culture tubes, or microtiter plate wells. Wells containing serial dilutions of antimicrobial agents are inoculated with a standard inoculum of a test organism. After which, the concentration of the drug that inhibits growth is determined by visual inspection or measuring turbidity.
The highest dilution (lowest concentration) of an antibiotic that completely inhibits growth is the MIC value for the test organism.
Determination of Antibody Titers
Antibody titer is the highest dilution (lowest concentration) of serum at which antigen-antibody reaction is observed. To determine antibody titer, serial dilutions of patient serum are prepared and assayed by various serological methods, such as ELISA.

In cases wherein high concentrations of antigen or antibody are anticipated, false-negative prozone or postpone phenomena, respectively, can be avoided by repeating the test using serial dilutions of the specimen.
Phage Plaque Assay
Bacteriophage plaque assay is done to grow isolated plaques of phage particles within a lawn of bacteria. To achieve a plaque count on plates of 100-250 pfu (plaque forming units), phage stock should be serially diluted.

Calculation of LD50
To calculate the lethal dose of viruses that do not cause recognizable effects in cell culture yet cause death in animals. Generally, 10-fold dilutions of viruses are made, and each dilution sample is injected into several sensitive animals.
After a suitable incubation period, the fraction of dead and live animals at each dilution is tabulated, and an end-point dilution is calculated. This is the dilution at which, for example, half of the injected animals die (the lethal dose for 50% or LD50).
Limitations
- Serial dilution is a labor-intensive process that is prone to multiple errors. To overcome these issues, bio-science companies are marketing various automated dilution equipment.
- The accuracy of the serial dilution and estimation of the viable count of bacteria depends on the homogenous dispersal of organisms in each dilution. Lack of proper pipetting or mixing of organisms may cause errors. Those errors can be minimized by giving hands-on training on proper pipetting, shaking each culture before sampling, and making several plates from each dilution.
- The viable count of bacteria **may not represent the entire living bacterial population.**It does not include organisms that may have died by the time plating was done; nor does it include organisms that cannot grow on the chosen medium. For example, anaerobic bacteria such as Clostridium perfringens, microaerophilic bacteria such as Campylobacter, and halophilic bacteria such as Vibrio parahemolyticus cannot grow on the standard methods agar.
Advantages of Serial Dilution
Serial dilutions are much easier to make as they are made by repeating the same dilution step over and over, using the previous dilution as the input for the next dilution. By plotting the dilution and the relative number of organisms (or concentration), the number of organisms (or concentrations) in any dilution can be estimated.
Thus serial dilution avoids the problems associated with cumbersome calculation and dilution required to make dilutions of various concentrations.
References and further readings
- Reynolds Jackie. Serial Dilution Protocols. American Society for Microbiology (2005).
- Serial Dilution Problem Help.The University of Vermont. https://www.uvm.edu/~btessman/calc/serhelp.html Accessed 11 November 2022.